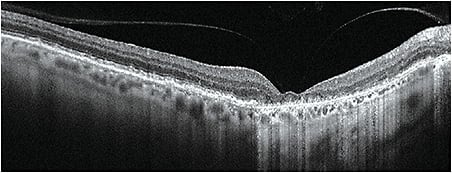

WELCOME TO THE AMD AND RETINA ISSUE
Compiled here are practical tips from a few of the articles that appear in this issue of Optometric Management.

START AMD IDENTIFICATION WITH OPHTHALMOSCOPY
 Ophthalmoscopy should be the first step in an early and accurate identification of age-related macular degeneration (AMD), writes Dr. Amanda S. Legge. Ophthalmoscopy can identify the presence of drusen, a diagnostic marker of AMD.
Ophthalmoscopy should be the first step in an early and accurate identification of age-related macular degeneration (AMD), writes Dr. Amanda S. Legge. Ophthalmoscopy can identify the presence of drusen, a diagnostic marker of AMD.
Preventing conversion to advanced AMD


LET PATIENTS KNOW THE LIMITS OF FULL-PAGE MAGNIFIERS
 It’s common for low vision patients to request a magnifier “large enough for an entire page,” write Dr. Bryan Wolynski and Dr. Andrea Zimmerman. However, these patients should be informed that such magnifiers give very little power, so they can’t provide much magnification for their larger field of view.
It’s common for low vision patients to request a magnifier “large enough for an entire page,” write Dr. Bryan Wolynski and Dr. Andrea Zimmerman. However, these patients should be informed that such magnifiers give very little power, so they can’t provide much magnification for their larger field of view.
Empower patients with magnification tools

DON’T JUST RELY ON THE PATIENT QUESTIONNAIRE
 When discussing a patient’s nutrition and ocular health needs, don’t just rely on the patient questionnaire; ask questions of the patient yourself, writes Dr. Jennifer Wademan. She makes sure to ask her AMD patients about diet, and, if need be, recommends they take an over-the-counter eye nutrition supplement to make sure they’re getting the nutrients they need.
When discussing a patient’s nutrition and ocular health needs, don’t just rely on the patient questionnaire; ask questions of the patient yourself, writes Dr. Jennifer Wademan. She makes sure to ask her AMD patients about diet, and, if need be, recommends they take an over-the-counter eye nutrition supplement to make sure they’re getting the nutrients they need.
Educate retina patients on eye-healthy nutrients

OFFER SUPPLEMENTS IN PRACTICE TO INCREASE PATIENT USE
 If you have patients that would benefit from use of nutritional supplements, consider offering them for sale in your clinic, writes Dr. Mark Schaeffer. At his clinic, when a supplement was recommended for a patient, they would only purchase it from an outside retailer about 5% of the time. However, when Dr. Schaeffer’s office began selling the supplements, that number increased to 60%.
If you have patients that would benefit from use of nutritional supplements, consider offering them for sale in your clinic, writes Dr. Mark Schaeffer. At his clinic, when a supplement was recommended for a patient, they would only purchase it from an outside retailer about 5% of the time. However, when Dr. Schaeffer’s office began selling the supplements, that number increased to 60%.
Dispense ocular nutritional supplements from your practice

USE LINK CLICKS TO JUDGE SOCIAL MEDIA EFFECTIVENESS
 This month’s “Social Media” column features an interview social media marketer Elise Darma. In order to effectively judge your practice’s social media reach, Ms. Darma recommends using link clicks as a barometer. Most platforms, such as Instagram and Facebook, have a way to gauge these online interactions, and they will tell you how many people are seeing and reacting to your social media posts.
This month’s “Social Media” column features an interview social media marketer Elise Darma. In order to effectively judge your practice’s social media reach, Ms. Darma recommends using link clicks as a barometer. Most platforms, such as Instagram and Facebook, have a way to gauge these online interactions, and they will tell you how many people are seeing and reacting to your social media posts.
Monitor your social media reach



